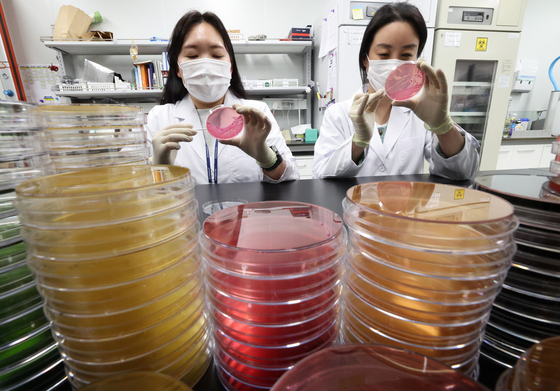
때이른 무더위 식중독 예방 철저
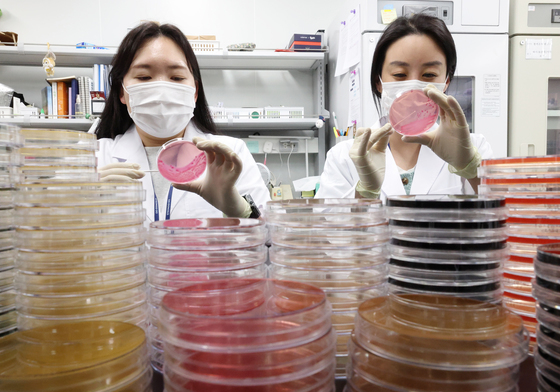
'때이른 무더위 식중독 조심하세요'
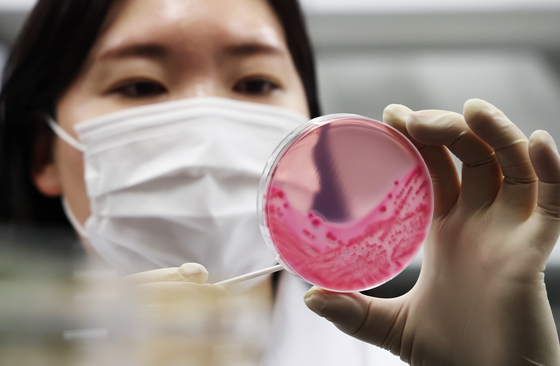
식중독 미리미리 예방해요

(평택=뉴스1) 김영운 기자 = 한미 연합연습 '자유의 방패'(Freedom Shield·FS) 연습을 하루 앞둔 8일 경기 평택시 팽성읍 주한미군기지 캠프 험프리스에 헬기와 장비들이 계류되어 있다.
한국과 미국은 오는 3월 9일부터 19일까지 연합방위태세 확립을 위해 상반기 연합훈련인 '자유의 방패 연습을 진행한다. 2026.3.8/뉴스1
kkyu6103@news1.kr
한국과 미국은 오는 3월 9일부터 19일까지 연합방위태세 확립을 위해 상반기 연합훈련인 '자유의 방패 연습을 진행한다. 2026.3.8/뉴스1
kkyu6103@news1.kr